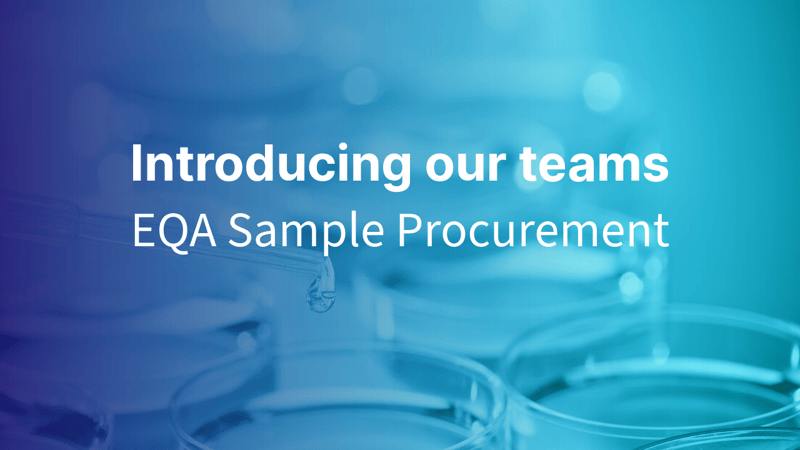

Introducing our teams: EQA sample procurement
The sample procurement team is one of three teams that together form our EQA Solutions department.
In addition to the coordination of EQA schemes, the sample procurement team is primarily responsible for the sourcing of almost all of our EQA samples.
The successful acquisition of reliable, homogenous, and stable samples is the cornerstone of high-quality EQA service. There are more than 200 different EQA schemes in our portfolio, each conducted from 1 to 12 times per year. Altogether, we deliver nearly 1,000 individual EQA rounds each year. As each round includes 1–5different samples, timely sample procurement forms a large and complex entity.
 We also source samples for new EQA pilot projects, continuously negotiate with new potential sample providers, and actively search for new and better sample formats and contents for our existing EQA products. Some of the samples sought for EQA rounds are rare, and finding them can sometimes require persistent effort.
We also source samples for new EQA pilot projects, continuously negotiate with new potential sample providers, and actively search for new and better sample formats and contents for our existing EQA products. Some of the samples sought for EQA rounds are rare, and finding them can sometimes require persistent effort.
We collaborate closely with all our EQA Coordinators and, of course, with our R&D team to provide the best possible samples for each EQA program.
There are five people in our team: EQA Coordinators Outi, Jaana and Yvonne, procurement manager Piritta and team leader Elina.